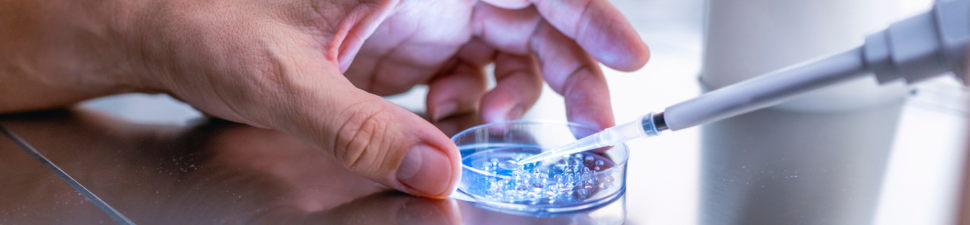

Nous avons le plaisir d’annoncer la nomination du Dr David Martin en tant que Médecin associé au sein de notre service.
Nous menons des projets de recherche clinique, fondamentale et translationnelle en collaboration avec l'EPFL et les Universités de Lausanne et Genève.
Nos projets de recherche clinique, fondamentale et translationnelle sont menés dans le cadre de plusieurs collaborations au sein des Universités de Lausanne et de Genève, de l'EPFL et du CHUV.
En chirurgie thoracique, ils portent sur les nouveaux traitements combinés pour le cancer pulmonaire localement avancé, le traitement photodynamique des tumeurs intéressant la plèvre, ainsi que sur la perfusion ex vivo des poumons lors de la transplantation pulmonaire afin de reconditionner/améliorer des poumons marginaux.
Nous avons le plaisir d’annoncer la nomination du Dr David Martin en tant que Médecin associé au sein de notre service.
La nutrition postopératoire après pancréatoduodénectomie reste un enjeu majeur en raison du risque élevé de complications et de dénutrition.